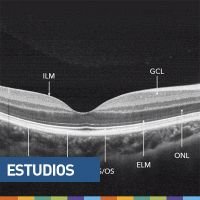
OCT a través de casos de la práctica diaria

ON DEMAND
CAO
Seleccione el video debajo de cada categoría
CAO - Clases y charlas en casa
-
Todo sobre oftalmología legal
Dres. Fernando Scattini, Patricia Visintín, Agustín Iglesias, Raúl Lassizuk, Ramón Galmarini y Roberto BorroneWebinar “Todo lo que quiso saber sobre oftalmología legal pero nunca se animó a preguntar”. Charlas: Conceptos jurídicos básicos, Documentación médica digital, Rol del médico legista, Enseñanzas de las demandas, Consentimiento informado en pandemia. -
Angio OCT
Dra. Camila ChalliolCharla “Angio OCT”, a cargo de la Dra. Camila Challiol. Esta clase se ofreció originalmente en el webinar “Yendo de la cama al living con el OCT” del ciclo “Clases y Charlas en Casa”, organizado por el CAO y coordinado por el Dr. Javier Casiraghi. -
Estudio del paciente con catarata
Dr. Marcelo ReinhartCharla “Estudio del paciente con catarata” a cargo del Dr. Marcelo Reinhart. Esta clase se ofreció durante el webinar “El ABC de la faco explicado por KVDRCABMB y otros más” del ciclo “Clases y Charlas en Casa”, organizado por el CAO y coordinado por el Dr. Javier Casiraghi. -
Uveítis con mate y bizcochitos
Dres. Carlos Ortega, Érika Hurtado, Cristóbal Couto y Ariel SchlaenWebinar “Uveítis con mate y bizcochitos”. Charlas: Introducción a la uveítis, Diagnóstico diferencial de uveítis anteriores, Diagnóstico diferencial de uveítis intermedias, Diagnóstico diferencial de retinitis, Diagnóstico diferencial de coroiditis. -
Preparación, incisiones y capsulorrexis
Dr. Sebastián AmadoCharla “Preparación, incisiones y capsulorrexis” a cargo del Dr. Sebastián Amado. Esta clase se ofreció durante el webinar “El ABC de la faco explicado por KVDRCABMB y otros más” del ciclo “Clases y Charlas en Casa”, organizado por el CAO y coordinado por el Dr. Javier Casiraghi. -
Evaluación del edema macular diabético
Dr. Joaquín BafalluyCharla “Evaluación del edema macular diabético”, a cargo del Dr. Joaquín Bafalluy. Esta clase se ofreció durante el webinar “Mácula de entrecasa” del ciclo “Clases y Charlas en Casa”, organizado por el CAO y coordinado por el Dr. Javier Casiraghi. -
Córnea desde el balcón
Dres. Gustavo Galperín, Alcides Lobbosco, Alfredo L. Roude, Tatiana Francisco y Pablo ChiaradíaWebinar “Córnea desde el balcón”. Charlas: Indicaciones quirúrgicas para ectasias, El pterigion y yo, Lesiones por ácidos y álcalis, Penfigoide ocular cicatrizal, ¿Cuándo se indica injerto endotelial? -
Esquema terapéutico de la coroidopatía central serosa
Dr. Andrés Bastién.Charla “Esquema terapéutico de la coroidopatía central serosa” a cargo del Dr. Andrés Bastién. Esta clase se ofreció durante el webinar “Mácula de entrecasa” del ciclo “Clases y Charlas en Casa”, organizado por el CAO y coordinado por el Dr. Javier Casiraghi. -
Sigue habiendo otras infecciones
Dres. Pablo Daponte, Fernando Pellegrino y María Julia Zunino, Lic. Julia Casale y Lic. Jefferson Da CunhaWebinar “Sigue habiendo otras infecciones”. Charlas: Endoftalmitis postquirúrgica, Amebas y algo más, Task Force Bioseguridad, Cómo limpiar y esterilizar el consultorio. -
Manejo y esquemas de tratamiento del EMD
Dr. Arturo AlezzandriniCharla “Manejo y esquemas de tratamiento del edema macular diabético” a cargo del Dr. Arturo Alezzandrini. Esta clase se ofreció originalmente durante el webinar “Mácula de entrecasa” del ciclo “Clases y Charlas en Casa”, organizado por el CAO y coordinado por el Dr. Javier Casiraghi. -
Oclusiones venosas de la retina: clínica y tratamiento
Dr. Eduardo ZabaloCharla “Oclusiones venosas de la retina: clínica y tratamiento” a cargo del Dr. Eduardo Zabalo. Esta clase se ofreció originalmente durante el webinar “Pan, queso y retina” del ciclo “Clases y Charlas en Casa”, organizado por el CAO y coordinado por el Dr. Javier Casiraghi. -
OCT-A en vasculopatías
Dr. Alejandro LavaqueCharla “OCT-A en vasculopatías” a cargo del Dr. Alejandro Lavaque. Esta clase se ofreció originalmente durante el webinar “Yendo de la cama al living con el OCT” del ciclo “Clases y Charlas en Casa”, organizado por el CAO y coordinado por el Dr. Javier Casiraghi. -
Orbitando y lagrimeando en la cocina
Dres. Emiliano Becerra, Raisa Abraham, Daniel Dilascio, Eduardo Rubin y Carlos MirWebinar “Orbitando y lagrimeando en la cocina”. Charlas: Epífora, Vía lagrimal alta, Celulitis orbitaria, Oftalmopatía de Graves, Rabdomiosarcoma. -
Plástica con el espejo al lado
Dres. Alejandra Billagra, Carlos Mir y Amalia AscarzaWebinar “Todo sobre plástica ocular”. Charlas: Trauma palpebral, Graves frente al espejo, Abordaje del paciente estético. -
Refractiva entre cuatro paredes
Dres. Ignacio Manzitti, Alberto Chialvo, Patricio Grayeb, Fernando Fuentes Bonthoux, Germán Bianchi y Carlos Ferroni.Webinar “Refractiva entre cuatro paredes”. Charlas: Selección de pacientes, Lasik-PRK, Lentes de fijación iridiana, ¿Cuándo y por qué ICL?, IPCL, Facorrefractiva. -
Lentes intraoculares
Dr. Ramiro Medina BoikoCharla “Lentes intraoculares” a cargo del Dr. Ramiro Medina Boiko. Esta clase se ofreció originalmente en el webinar “El ABC de la faco explicado por KVDRCABMB y otros más” del ciclo “Clases y Charlas en Casa”, organizado por el CAO y coordinado por el Dr. Javier Casiraghi. -
Facodinamia
Dr. Fernando CarideCharla “Facodinamia” a cargo del Dr. Fernando Caride. Esta clase se ofreció originalmente en el webinar “El ABC de la faco explicado por KVDRCABMB y otros más” del ciclo “Clases y Charlas en Casa”, organizado por el CAO y coordinado por el Dr. Javier Casiraghi. -
Con los ojos frente a la pantalla (Parte 1)
Dres. Martín Berra y Florencia ValvecchiaWebinar “Con los ojos frente a la pantalla (Parte 1)”. Charlas: Algoritmo diagnóstico en ojo seco. Blefaritis por demodex. -
Con los ojos frente a la pantalla (Parte 2)
Dres. Francisco Lucero Saá, Alejandro Aguilar y Alejo VercesiWebinar “Con los ojos frente a la pantalla (Parte 2)”. Charlas: Disfunción glandular con IPL, Síndrome de Sjögren, Insuficiencia limbar total. -
Pizza & Beer con los Jóvenes Oftalmólogos (Parte 1)
Dres. Mariano Cotic y Martina LarroudéWebinar “Pizza & Beer con los Jóvenes Oftalmólogos (Parte 1)”. Charlas: Sorpresa post faco, Úlceras neurotróficas. -
Pizza & Beer con los Jóvenes Oftalmólogos (Parte 2)
Dres. Luciano Perrone y Andrés BenattiWebinar “Pizza & Beer con los Jóvenes Oftalmólogos (Parte 2). Charlas: Pizza, cerveza y complicaciones, Queratocono: tratamiento con asimétricos y técnica híbrida. -
Glaucomateando (Parte 1)
Dres. Jorge Lynch, Ignacio LischinskyWebinar “Glaucomateando (Parte 1)”. Charlas: Hipertensión ocular o glaucoma, ¿Cómo establecer la PIO target? -
Glaucomateando (Parte 2)
Dres. Pablo Deromedis y Javier CasiraghiWebinar “Glaucomateando (Parte 2)”. Charlas: Estrategias de tratamiento médico, ¿Cuándo hacer SLT?
Desayunando con el CAO
-
Jóvenes y Rebecos: Ciencia y algo más (parte 1)
Dres. Armendariz, Grigera, Agüero, Barlatey, Balbarrey, Serrano y BareiroWebinar “Desayunando con el CAO: Jóvenes y Rebecos – Desayuno saludable, ciencia y algo más (parte 1). Charlas: Desayuno fit, Coroiditis multifocal, Clase de meditación, FACOVID, Mi primer LIO premium, Úlcera refractaria al tratamiento, Queratitis infecciosa, Clase de yoga, Receta de un trago. -
Jóvenes y Rebecos: Ciencia y algo más (parte 2)
Dres. González, Kantor, Cirimarco, Castro Barrientos, Montero, Gutiérrez Flores y DawidowiczWebinar “Desayunando con el CAO: Jóvenes y Rebecos – Desayuno saludable, ciencia y algo más (parte 2). Charlas: Yoga ocular, LIO tórico, Nutrición fit plant-based, Corticoides en EMD recidivante, Proliferación angiomatosa retiniana, Enfermedad de Best, Síndrome de Terson, Rediseñando la nueva normalidad. -
Clínica y tecnología práctica
Dres. Lobbosco, Torres, Acosta, Desio, Galanti y RamírezWebinar “Desayunando con el CAO: AEO – Clínica y tecnología práctica”. Charlas: Cirugía combinada de glaucoma, El camaleón rebelde desafiando a la córnea, Glaucoma agudo, cámara estrecha, ¿iridotomía?, Aplicación de nuevas tecnologías en oftalmología. -
Presbicia: actualizando el enfoque
Dres. Just Tiscornia, Azpelicueta, Benozzi, Leiro, Gimeno y Di Biase.Webinar “Desayunando con el CAO: SAP – Presbicia: Actualizando en enfoque”. Charlas: Alternativas médicas y quirúrgicas para la presbicia, Método Benozzi: tratamiento farmacológico de la presbicia, Acomodación, diagnóstico por imágenes, Cirugía premium en pacientes post tratamiento farmacológico, Tratamiento médico de la presbicia post LASIK en hipermétropes. -
Desayunando con el CAO: ACHO y SOMI
Dras. Miño y ArkwrightWebinar “Desayunando con el CAO: ACHO/SOMI”. Charlas: Carcinoma basocelular, Retina-uveítis. -
Desayunando con el CAO: UNC
Dres. Vettorazzi, Maffrand y RemondaWebinar “Desayunando con el CAO: UNC”. Charlas: Agujeros maculares y flaps de MLI, Glaucoma de tensión normal, ¿es? ¿Y ahora?, La culpa no es del chancho... -
Multitasking patagónico
Dres. Croce, Vater, Parmo, Roveran y SuárezWebinar “Desayunando con el CAO: AORN/AAO/AON – Multitasking patagónico”. Temas: Retinopatía diabética: cuándo y cómo tratarla, Úlceras inmunológicas: mucho más que un defecto epitelial, Tipos de cirugía refractiva, Catarata traumática, Pseudotumor cerebri en niños, Proyecto máscara de presión positiva. -
Desayunando con el CAO: UAI
Dres. Vercesi, Bercovich y FerroniWebinar “Desayunando con el CAO: UAI. Temas: Cuando la presión no quiere bajar: ¿cómo seguimos?, Absceso corneal: injerto en caliente, Insuficiencia limbar: pasado, presente y futuro. -
Un tumor: mi diagnóstico
Dres. Macchió, Reviglio, Crim, Matach, Urrets Zavalía y TorresWebinar “Desayunando con el CAO: UCC - Un tumor: mi diagnóstico”. Temas: Casos clínicos, Cuadros clínicos, Tumor, Lesión tumoral coroidea. -
Superficie ocular
Dres. Macchió, Endrek, Favalli, Liviero, Romera VerziniWebinar “Desayunando con el CAO: SOC – Superficie ocular”. Temas: COVID-19, Blefaritis por demodex, Síndrome por computadora, Cirugía de pterigion con adhesivo tisular. -
OCT a través de casos de la práctica diaria
Dres. Estrago, Kotlik, Molino, CasanovaWebinar “Desayunando con el CAO: SARyV - OCT a través de casos de la práctica diaria”. Temas: OCT, Autofluorescencia, Fisiopatología del EMD, MER y TVM. -
Desayunando con el CAO: SACRyC y AsAG
Dres. Aiquel, Ribola, Páez Soria, Rinaudo.Webinar “Desayunando con el CAO: SACRyC/AsAG”. Temas: Nanoftalmos, MIGS, PK: síndrome de Urrets-Zavalía, Trasplante y glaucoma. -
Retina en el Far West
Dres. Ripoll, Campayo, Waisman, LarreaWebinar “Desayunando con el CAO: SOSJ y UCCuyo”. Temas: DR regmatógeno, Tips vitrectomía en RD, Agujero macular en casos, Tips en agujero macular. -
De telemedicina a cirugía en pandemia
Dres. Montero, Ortiz Basso, VeneroWebinar “Desayunando con el CAO: APO – Desde la telemedicina hasta la cirugía en los tiempos de pandemia”. Temas: Pterigión, Ceguera por diabetes y teleoftalmología, Cómo ser un cirujano exitoso.
CAO - OTM
-
On The Minute: Complementarios
Dres. Armendariz, Grigera, Agüero, Barlatey, Balbarrey, Serrano y BareiroOftalmología On The Minute (OTM): Complementarios. Temas: Eco en melanoma, PFC en RDP, Paquicoroideos, Eco en endoftalmitis, Iluminación transescleral, Chequeo tonómetro, CRCS, Imágenes multicolor. -
On The Minute: Córnea
Dres. Mir, Bonamino y NavarroOftalmología On The Minute (OTM): Córnea. Temas: Belin Ambrosio, DSAEK, Demodex, Sutura de córnea. -
On The Minute: FacoTime!
Dres. Kantor, Cotic, Magnetto, Peirano y ErtolaOftalmología On The Minute (OTM): FacoTime! Temas: LIO tórico, Malyugin, Anillo de cápsula, Ganchos de iris, Scaffold, Stop & Chop, Anillo y gancho. -
On The Minute: Neurooftalmo
Dres. Ceballos, Salina, Zago, Antonelli, de Zavalía, Vouilloz y Giménez LunaOftalmología On The Minute (OTM): Neurooftalmo. Temas: Ptosis palpebral, Movimientos oculares, Pseudotumor cerebro, Parálisis del VI, Test de alineación, Parálisis del III, Blefaroespasmo. -
Rebecos 2019
"Review del Torneo de Penales Rebecos Paraná 2019. Terna definitiva: 1° puesto: Instituto Santa Lucía de Paraná (Dras. María Ayelén Rosa Serb, Antonella Orbegozo y Laura Glaser). 2° puesto: Hospital Lagleyze (Dras. Luciana Ferrara, Julieta Graciani y Florencia Parisi). 3° puesto: Centro de Ojos Lanús (Dras. Antonella Fedorko, Carla Miranda y Macarena Biga). Más información en www.oftalmologos.org.ar/rebecos."
CAO - Entrevista
-
¿Cómo sigue mi vida al terminar una residencia?
Comité Ejecutivo CAO y Dres. Anargyros, Colom y MonteroEntrevista “¿Cómo sigue mi vida al terminar una residencia?”. Tres oftalmólogos jóvenes entrevistaron a 8 integrantes del Comité Ejecutivo del CAO siguiendo estos ejes: ¿Recomendarían observerships en el exterior? ¿Beneficios de la participación activa en el CAO? ¿Requisitos para trabajar en el interior? -
FAQ Seguros Médicos
Pedro Galfrascoli, Patricia Quian y Dres. Fabiana Compiani, Raúl Lassizuk, Nora Carballal y Gustavo BodinoEntrevista a Pedro Galfrascoli y Patricia Quian, representantes de Seguros Médicos SA, la empresa de seguros de los socios del CAO.